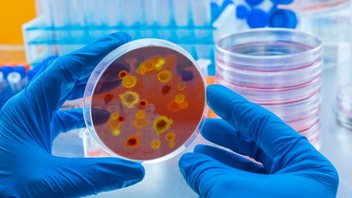
img

Новини за тегом "Комаровський"
21 січня 2025
24 травня 2022
3 лютого 2022
 Сховати подалі телевізор і не тільки: Комаровський розповів, як прийти до тями після коронавірусу
Сховати подалі телевізор і не тільки: Комаровський розповів, як прийти до тями після коронавірусу
Суспільство
18 січня 2022
31 грудня 2021
22 листопада 2021
11 грудня 2020
 Може загрожувати життю: Комаровський вказав на важливий нюанс з втратою нюху при COVID-19
Може загрожувати життю: Комаровський вказав на важливий нюанс з втратою нюху при COVID-19
Суспільство
8 травня 2020
23 квітня 2020
5 квітня 2020
З собаками можна, а з дітьми ні: Комаровський вибухнув гнівом через карантин в Україні, відео
Суспільство
29 березня 2020
26 березня 2020
25 березня 2020
24 березня 2020
22 березня 2020
19 березня 2020
Як поводитися з мобільниками, щоб не підхопити коронавірус: поради від доктора Комаровського
Суспільство